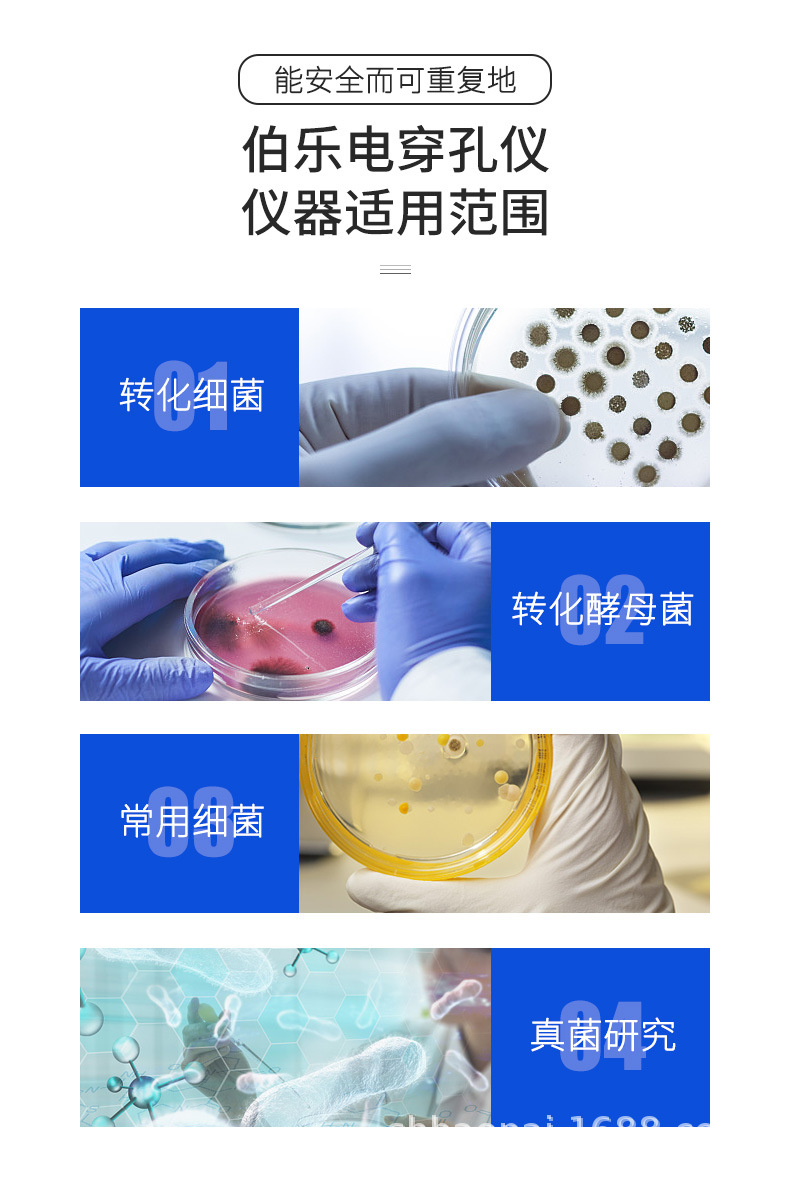
13.jpg

Американский электрошоковый аппарат MicroPulser / GenePulserXcell для электрофореза в наличии
Вес:
0.10 кг
Всего продаж:
10 шт.
Минимальное количество для заказа:
1 шт.
Американский электрошоковый аппарат MicroPulser / GenePulserXcell для электрофореза в наличии
от 2 600.00 ₽ за 1 шт.
-21%
2 600.00 ₽
Доставка по Китаю включена в цену
Оптом
от 1 шт.
2 600.00 ₽
Описание

Характеристики
Происхождение:
Шанхай
Импортировать ли:
нет
Номер заказа:
Электрическое перфорационное устройство Bol
размер:
Электрическое перфорационное устройство Bol
номер товара:
Электрическое перфорационное устройство Bol
напряжение:
220
Обработка и настройка:
является
тип:
Электрическое перфорационное устройство Bol
бренд:
Болле
Область применения:
Электрическое перфорационное устройство Bol
Модель:
Электрическое перфорационное устройство Bol
Емкость образца:
Электрическое перфорационное устройство Bol
Спецификация:
Депозит электрического перфорационного устройства Boluo
Заниматься ли исключительно поставками товаров для трансграничного экспорта:
нет
О продавце
Имя:
Оценка сервиса:
4.0
Оценка логистики:
4.1
Оценка споров и жалоб:
5.0
Оценка предложения:
5.0
Оценка консультации:
3.0
repeatPurchasePercent:
0.18055555555555552
afterSalesExperienceScore:
5.0
Американский электрошоковый аппарат MicroPulser / GenePulserXcell для электрофореза в наличии
2 600.00 ₽
2 600.00 ₽